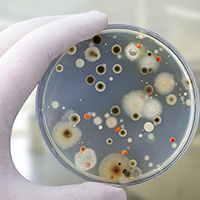
Биопрепараты
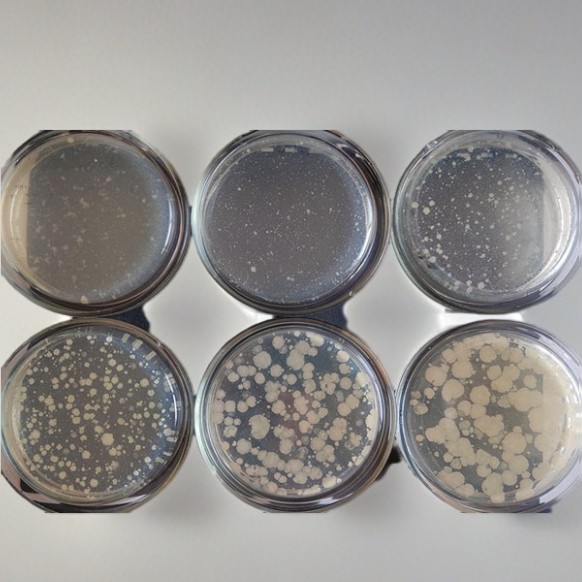
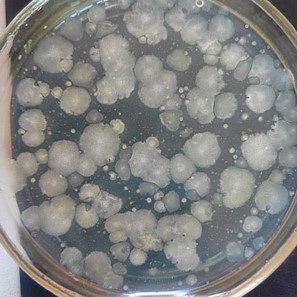
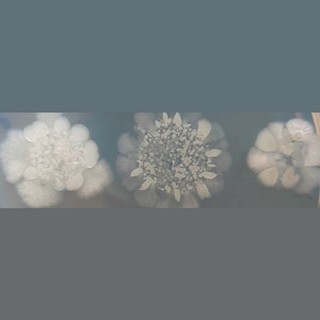
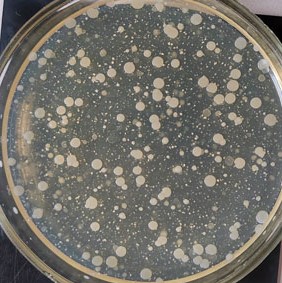
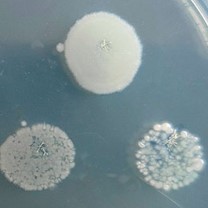
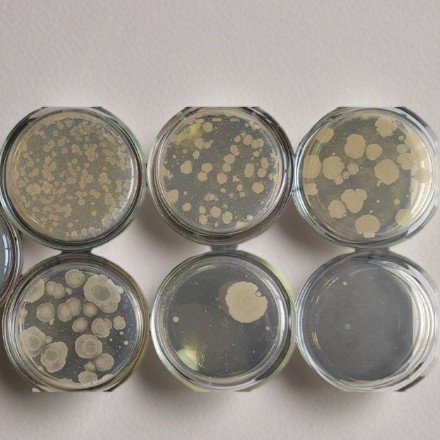
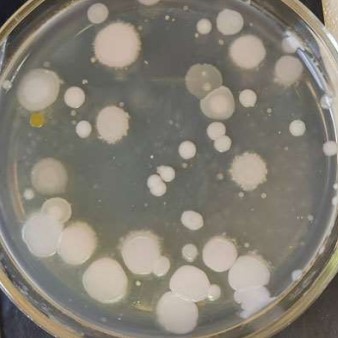

Товар всегда в наличии на складе. Мы готовы к бесперебойным
поставкам любых
объемов.






Биопрепараты «Илья Муромец»












Биопрепараты для септиков и выгребных ям

Деградация органики: белков, жиров, целлюлозы

Очистка поверхностей от нефтепродуктов

Снижение запаха

Стабильная работа БОС в холодную погоду

Переработка растительной органики в компост

Переработка отходов животноводческих ферм

Рекультивация почв, разложение нефтепродуктов

Очистка оборотной воды автомоек

Запуск новых БОС, восстановление работы

Очистка канализации, жироуловителя

Уменьшение донного осадка

Предотвращение зацветания водоемов

Очистка сточных вод от хлора

Деградация органики в аэробной и анаэробной зоне БОС

Чем выше концентрация активных микроорганизмов в составе средства, тем быстрее и эффективнее они справятся с отходами.

Если бактерий недостаточно для объема отходов, они не справятся и погибнут. Напротив избыток приведет к конкуренции за ресурсы, что снизит эффективность.

После переработки отходов бактериями в септике остается жидкость, которую можно откачать насосом. Чтобы избежать засорения техники, используйте фильтр — он задержит остатки ила.

После переработки бактерии оставляют осадок. Чем меньше осадка — тем лучше функционирует септик и снижается частота его чистки.

Живые бактерии активны только в течение указанного периода. Просроченный препарат уже не имеет никакой эффективности.

При первом запуске септика, выбирайте средства с пометкой «для первичного применения». В их составе есть питательные вещества, которые ускоряют создание активной колонии.

Одни виды микробов расщепляют жиры, другие — органику, третьи — мочевину. Чем шире состав препарата, тем больше задач он может решить.

Вода, очищенная анаэробными или аэробными бактериями, не подходит для питья! Её можно применять только для полива растений или технических нужд.
Если бактерии не справляются с отходами (появился запах или застой отходов) добавьте новую порцию препарата. Возможно, прежняя колония погибла из-за перегрузки или агрессивной среды.
Наши биопрепараты проходят регулярное тестирование в ведущих научных центрах и аккредитованных лабораториях, что подтверждает их эффективность, безопасность и соответствие высоким стандартам качества. В рамках научно-исследовательской деятельности мы постоянно разрабатываем новые биологические штаммы, оптимизируем питательные среды и внедряем прорывные технологии для ускорения и повышения эффективности процессов активации.
Наша приоритетная задача — обеспечить стабильную работу биопрепаратов в более агрессивных и экстремальных условиях, внедряя инновационные решения и повышая их устойчивость за счет современных биотехнологических подходов.
Ниже представлен пример исследований по количеству микроорганизмов при различных условиях выдержки образцов (при выдержке 2-3 часа и 24 часа), что демонстрирует динамику их размножения и активности.


При глубинном культивировании под поверхностью и в толще агара вырастают факультативные анаэробы, аэробные бактерии вырастают на поверхности плотной агаризованной среды.
Колонии в толще питательной среды (глубинные колонии) обычно имеют форму лодочки, линзы или зерна чечевицы.
Просмотр посевов осуществляется каждый день.
Результаты оцениваются по каждой пробе отдельно.
Подсчитывают количество колоний на тех чашках, где их выросло от 15 до 300,
суммируют и находят среднее арифметическое из них.
Допускается учитывать колонии с помощью лупы с 5х увеличением.
Количество микроорганизмов в 1 г продукта (X) вычисляют по формуле X = а x 10N / q, где:
Результаты анализа выражаются числом от 1,0 до 9,9, умноженным на 10 в соответствующей степени.
Метод основан на размещении определенного объёма исследуемой бактериальной суспензии в чашке Петри с агаризованной питательной средой в виде фиксированного количества отдельных капель в соответствии с шаблоном. После инкубации подсчитываются колонии в каплях и устанавливают общее количество КОЕ в определенном объеме.
Для определения количества жизнеспособных бактерий методом Drop plate приготовливаются серийные 10-кратные разведения образцов в 0.9% NaCl. Суспензии из каждого разведения переносится на чашки с агаризованной средой.
 Рисунок 1
Рисунок 1 Рисунок 2
Рисунок 2 Рисунок 3
Рисунок 3 Рисунок 4
Рисунок 4 Рисунок 5
Рисунок 5 Рисунок 6
Рисунок 6Таблица 1. Количество аэробных и факультативно-анаэробных бактерий в составе образца №1
| Время выдерживания пробы при комнатной температуре (22 +/- 1) °C | Капельно-чашечный метод (Drop Plate анализ) | Метод глубинного посева | |||
| Поверхностные колонии, КОЕ / г | Поверхностные колонии, КОЕ / г | Глубинные колонии, КОЕ / г | Общее количество, КОЕ / г | ||
| 3 часа | 1,6 × 109 | 1,1 × 109 | 2,8 × 109 | 3,9 × 109 | |
| 24 часа | 1,7 × 1010 | 3,1 × 1010 | 1,3 × 1011 | 1,6 × 1011 | |
Таким образом, общее количество микроорганизмов на грамм исследуемого образца после выдерживания пробы в течение 3 часов составило 3,9 х 109 КОЕ. Увеличение времени выдерживания пробы до 24 часов привело к возрастанию общего количества микроорганизмов до 1,6 х 1011 КОЕ.
 Рисунок 1
Рисунок 1 Рисунок 2
Рисунок 2 Рисунок 3
Рисунок 3 Рисунок 4
Рисунок 4 Рисунок 5
Рисунок 5 Рисунок 6
Рисунок 6Таблица 1. Количество аэробных и факультативно-анаэробных бактерий в составе образца №2
| Время выдерживания пробы при комнатной температуре (22 +/- 1) °C | Капельно-чашечный метод (Drop Plate анализ) | Метод глубинного посева | |||
| Поверхностные колонии, КОЕ / г | Поверхностные колонии, КОЕ / г | Глубинные колонии, КОЕ / г | Общее количество, КОЕ / г | ||
| 3 часа | 8,1 × 109 | 3,2 × 109 | 3,5 × 1010 | 3,8 × 1010 | |
| 24 часа | 3,3 × 1011 | 2,5 × 1011 | 4,3 × 1012 | 4,5 × 1012 | |
Таким образом, общее количество микроорганизмов на грамм исследуемого образца после выдерживания пробы в течение 3 часов составило 3,8 х 1010 КОЕ. Увеличение времени выдерживания пробы до 24 часов привело возрастанию общего количества микроорганизмов до 4,5 х 1012 КОЕ.
 Рисунок 1
Рисунок 1 Рисунок 2
Рисунок 2 Рисунок 3
Рисунок 3 Рисунок 4
Рисунок 4 Рисунок 5
Рисунок 5 Рисунок 6
Рисунок 6Таблица 1. Количество аэробных и факультативно-анаэробных бактерий в составе образца №3
| Время выдерживания пробы при комнатной температуре (22 +/- 1) °C | Капельно-чашечный метод (Drop Plate анализ) | Метод глубинного посева | |||
| Поверхностные колонии, КОЕ / г | Поверхностные колонии, КОЕ / г | Глубинные колонии, КОЕ / г | Общее количество, КОЕ / г | ||
| 3 часа | 3,0 × 108 | 0,7 × 108 | 2,6 × 108 | 3,3 × 108 | |
| 24 часа | 5,0 × 109 | 2,5 × 109 | 2,3 × 1010 | 2,6 × 1010 | |
Таким образом, общее количество микроорганизмов на грамм исследуемого образца после выдерживания пробы в течение 3 часов составило 3,3 х 108 КОЕ. Увеличение времени выдерживания пробы до 24 часов привело возрастанию общего количества микроорганизмов до 2,6 х1010 КОЕ.
Таким образом, с использованием методов культивирования бактерий на поверхности и в толще плотных агаризованных питательных сред, установлено, что количество аэробных и факультативно-анаэробных бактерий в составе биопрепаратов напрямую зависит от времени предварительного выдерживания образцов в тёплой, не хлорированной воде (от 2 до 24 часов) и является характерным для каждого конкретного образца.
Количество микроорганизмов варьируется от 108 до 1010 при выдерживании образцов в течение 3 часов, и от 1010 до 1012 при выдерживании образцов в течение 24 часов.
Наши преимущества





















































Вас интересуют: Биопрепарат Bacti Bio, Bacti Bio, BioRemove, Biozim, Биобактерии для септиков, Биобактерии для туалета, Биобактерии для выгребныхГорыныч для септика, биопрепарат Горыныч, бактерии Горыныч, средство Горыныч, Горыныч для выгребных ям, Novozymes, Sanfor для септика, BioExpert для септика, биосепт для септика, Санэкс, Доктор Робик, Dr Robik, Тамир биопрепарат, Тамир для выгребных ям, Тамир для септиков, Septicsol, Ликвазим, Биосепт, средство Биобак, Биобак для септиков, Артель Золотарь, средство Летом и Зимой, Septon для септиков, Latrin Bio, Латрин Био, Биоактиватор для септиков, бактерии для септика, биоактиватор для выгребных, биопрепарат для выгребных, биопрепарат для септиков, биопрепарат для туалета, бактерии для выгребных, бактерии для туалета, биоактиватор для туалета, Бактерии для сточных, биопрепараты для сточных, русский богатырь биопрепарат, Sanfor Bio-активатор, Unibac Effect, БашИнком Удачный, Уборная сила, BIOSREDA, BioBac, Аэробные бактерии, Roetech бактерии, Roetech для септиков, Sanfor Биоактиватор, биоактиватор для стоков, бактерии для септика, бактерии для стоков, бактерии для туалета, бактерии для канализации, биоактиватор для канализации, бактерии для очистных, биопрепараты для очистных, биопрепараты для жироуловителя, бактерии в жироуловителе, очистка стоков бактериями
Если вас интересуют перечисленные товары, то мы, как производители, можем вам предложить инновационный, высококачественный и высокоэффективный биопрепарат «Илья Муромец» на выгодных условиях и низкой цене, с быстрой доставкой по всей России!

Задайте их нашему специалисту
Или позвоните по телефону